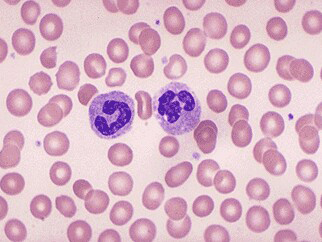
2015临床医师:血液系统1-文都公务员考试网

2015临床医师:血液系统1-文都公务员考试网
322x242 - 87KB - JPEG

我国最常见的血红蛋白病是()
307x206 - 24KB - JPEG

鑫鑫教学主营:生物切片、标本模型(人血涂片)_
450x407 - 23KB - JPEG

ed blood cells on smear, microscopic (血涂片中
504x331 - 89KB - JPEG

血涂片显示myelomonocytic白血病。涂片显示大
450x326 - 41KB - JPEG

血涂片
600x422 - 368KB - JPEG

体检中乳酸脱氢酶急剧升高原来是因为PNH - 检
1580x1053 - 994KB - JPEG

正常人单核细胞白血球与红细胞在外周血涂片的
1200x793 - 599KB - JPEG
十分钟外周血涂片全了解! - 今日头条(www.tou
305x211 - 8KB - JPEG

血小板计数正常就没问题了?还要注意这个…
490x366 - 104KB - JPEG

正常人红细胞或红细胞在外周血涂片中,Wright
1200x800 - 345KB - JPEG

恶性贫血。光显微图血涂片的病人患有恶性巨成
1280x862 - 139KB - JPEG

正常血常规报告下的棘形红细胞增多症
1080x535 - 239KB - JPEG

光显微图血涂片的急性淋巴细胞白血病all患者显
1280x854 - 248KB - JPEG

血涂片中的淋巴细胞
1200x800 - 542KB - JPEG
正常人的血涂片中可以见到哪种细胞.展开全部 正常人的血涂片中可以见到的细胞有:红细胞、白细胞。血小板
病情描述(发病时间、主要症状、症状变化等):血涂片结果如何判断是否正常曾经治疗情况和效果:外周血细胞
血涂片的显微镜检查是血液细胞学检查的基本方法,应用极广。特别是对各种血液病的诊断有很大价值。但血片
血涂片是血液细胞学检查的基本方法,应用极广,特别是对各种血液病的诊断有很大血涂片的制作及血细胞观察
百姓健康网为您带来血涂片正常值,血涂片正常范围等相关资料.帮助您全面了解血涂片检查相关知识,让您能清楚
血涂片正常值是多少?关于血涂片的检查结果介绍和分析,血涂片临床意义介绍等等.
血涂片报告正常 血涂片报告正常:涂片 Bao 告 血涂片检查什么病 外周血涂片检 Cha 的目的 外周血涂片报告
您好,目前人工血液涂片检查没有发现幼稚血细胞,没有发现幼稚细胞血涂片报告是不是就不写 血常规 全正常
血涂片是血液细胞学检查的基本方法,应用极广。特别是对各种血液病的诊断有很大价值。但血片制备和染色不良